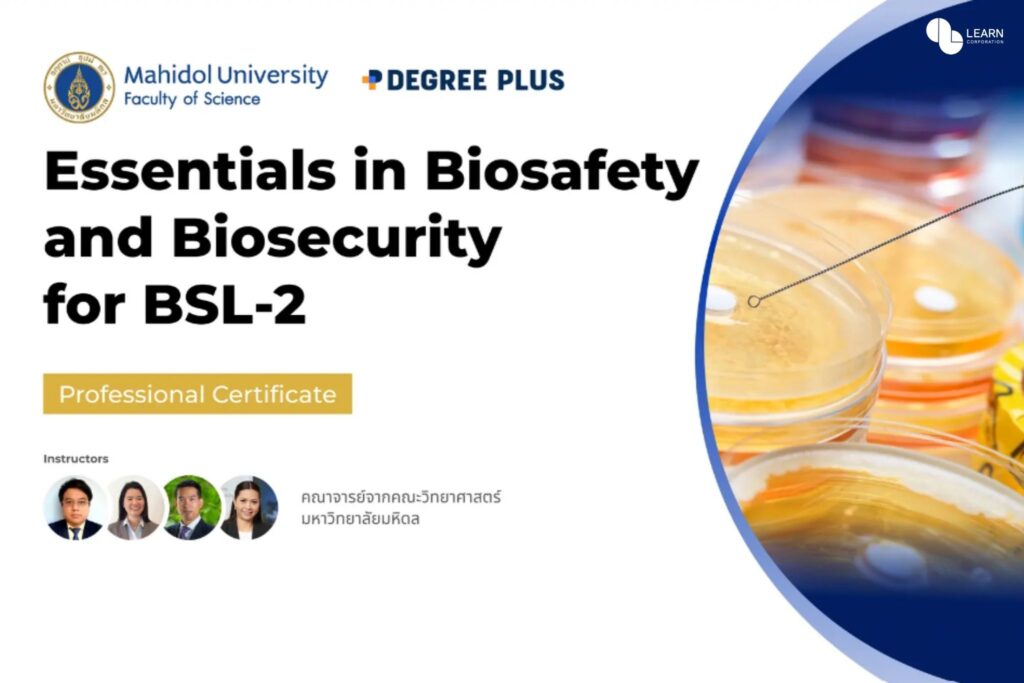

LEARN ยกระดับ Professional Upskilling คนไทย ส่ง Degree Plus เปิดหลักสูตร Securities Class Action Lawsuit และ Biosafety BSL-2 หลักสูตรการเรียนแบบ Hybrid ที่แรกและที่เดียวในไทย!
LEARN Corporation ยกระดับการอัปสกิลอาชีพคนไทย ส่ง Degree Plus จับมือกับสถาบันชั้นนำระดับประเทศ เปิดหลักสูตรอัปสกิลอาชีพ (Professional Certifications) แบบ Hybrid ที่ผสานการเรียนออฟไลน์และออนไลน์เข้าด้วยกัน ในหลักสูตร “Securities Class Action Lawsuit” และ “Essentials in Biosafety and Biosecurity for BSL-2” ที่แรกและที่เดียวในไทย เพื่อส่งเสริมทักษะอาชีพพร้อมดึงศักยภาพบุคลากรไทยทัดเทียมสากล

Degree Plus แพลตฟอร์มรวมคอร์สเรียนอัปสกิลอาชีพจากมหาวิทยาลัยชั้นนำ ในเครือ LEARN Corporation เล็งเห็นถึงความสำคัญของการเรียนรู้ในกลุ่มวิชาชีพยุคใหม่ที่ต้องอาศัยการรับรองและการพัฒนาองค์ความรู้ตลอดการประกอบวิชาชีพ จึงร่วมมือกับสมาคมส่งเสริมผู้ลงทุนไทย (TIA) คณะนิติศาสตร์ จุฬาลงกรณ์มหาวิทยาลัย และคณะวิทยาศาสตร์ มหาวิทยาลัยมหิดล เปิดหลักสูตรอัปสกิลอาชีพ (Professional Certifications) แบบ Hybrid หรือแบบผสมผสาน ที่เปิดสอนภาคทฤษฎีแบบออนไลน์ควบคู่กับการอบรมภาคปฏิบัติแบบออฟไลน์ ช่วยให้บุคลากรเข้าถึงบทเรียนได้ง่ายและทบทวนบทเรียนได้ไม่จำกัด เพื่อส่งเสริมการพัฒนาศักยภาพวิชาชีพไทยให้มีมาตรฐานเทียบเท่าสากล ได้แก่ หลักสูตร Securities Class Action Lawsuit หรือหลักสูตรด้านกฎหมายการดำเนินคดีหลักทรัพย์แบบกลุ่ม โดย สมาคมส่งเสริมผู้ลงทุนไทย (TIA) และคณะนิติศาสตร์ จุฬาลงกรณ์มหาวิทยาลัย ที่ช่วยสร้างความเข้าใจการฟ้องร้องคดีแบบกลุ่มโดยละเอียด ตั้งแต่ความรู้ด้านพื้นฐานกฎหมายหลักทรัพย์ การดำเนินคดีความแบบกลุ่ม การกระทำผิด ตลอดจนการฟ้องร้อง ตอบสนองความต้องการของบุคลากรด้านกฎหมายอย่างครอบคลุม อีกทั้งผู้เรียนจะได้เรียนรู้จากประสบการณ์จริงของผู้พิพากษา นักวิชาการ และทนายความผู้เชี่ยวชาญการทำคดีกลุ่มโดยตรง นอกจากนี้ Degree Plus ยังต่อยอดความรู้ด้านวิทยาศาสตร์ชีวภาพด้วยหลักสูตร Essentials in Biosafety and Biosecurity for BSL-2 หรือ หลักสูตรอบรมความปลอดภัยทางชีวภาพและการรักษาความปลอดภัยทางชีวภาพระดับ BSL-2 รุ่นที่ 2 โดย คณะวิทยาศาสตร์ มหาวิทยาลัยมหิดล เพื่อเสริมสร้างทักษะการวิจัยในห้องปฏิบัติการทางชีวภาพตามมาตรฐานที่กฎหมายกำหนดและเป็นไปตามแนวปฏิบัติสากล โดยผู้ที่สำเร็จหลักสูตรจะได้รับใบประกาศนียบัตรผ่านการอบรมซึ่งสามารถใช้เป็นหลักฐานประกอบการขอรับรองโครงการความปลอดภัยทางชีวภาพได้ตามกฎหมายประเทศไทย และหลักสูตรดังกล่าวผ่านการรับรองโดยกรมวิทยาศาสตร์การแพทย์และยังเป็นหลักสูตรแรกในประเทศไทย (เลขที่ สธ 0621.06/7019) อีกด้วย


นายวรพล รัตนพันธ์ ผู้จัดการทั่วไปและผู้ร่วมก่อตั้ง บริษัท ดีกรีพลัส จำกัด กล่าวว่า “จากพฤติกรรมของคนยุคใหม่ที่มีดีมานด์ด้านต่าง ๆ บนออนไลน์มากขึ้น Degree Plus จึงร่วมมือกับสถาบันชั้นนำของไทย พัฒนาหลักสูตรการอัปสกิลอาชีพแบบ Hybrid เพื่อส่งเสริมการเรียนรู้ในกลุ่มอาชีพที่ต้องอาศัยการอบรม พัฒนาทักษะเฉพาะ และอัปเดตองค์ความรู้อย่างสม่ำเสมอ หลักสูตรดังกล่าวต้องมีคุณภาพเทียบเท่ากับหลักสูตรรูปแบบเดิมและผ่านการรับรองโดยสถาบันชั้นนำระดับประเทศ เพื่อคงมาตรฐานองค์ความรู้และความน่าเชื่อถือของวิชาชีพนั้น ๆ โดยเฟสแรกเราเริ่มต้นหลักสูตร Hybrid ในกลุ่มวิชาชีพด้านกฎหมายและวิทยาศาสตร์ชีวภาพ ซึ่งเป็นกลุ่มที่มีบุคลากรคุณภาพ เป็นกำลังสำคัญของสังคมและสามารถช่วยขับเคลื่อนเศรษฐกิจภาพรวมได้ ในอนาคตเรามีเป้าหมายจะขยายหลักสูตร Hybrid ให้ครอบคลุมวิชาชีพอื่น ๆ เพื่อการเข้าถึงที่ง่าย กระจายการเรียนรู้ให้ครอบคลุม อีกทั้งยังช่วยพัฒนาศักยภาพบุคลากรไทยทัดเทียมนานาประเทศต่อไป”
ผู้ที่สนใจสูตร “Securities Class Action Lawsuit” และ “Essentials in Biosafety and Biosecurity for BSL-2” สูตรอัปสกิลอาชีพแบบ Hybrid ที่แรกที่เดียวในไทย สามารถดูรายละเอียดเพิ่มเติมที่ https://store.degree.plus

